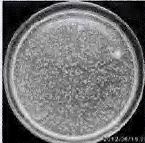
image039.jpg
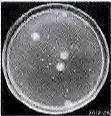
image053.jpg

纳米氧化钛整理涤纶织物及其抗菌性研究yd16417
孙飞翎1,郑敏2 1、现代丝绸国家实验室, 江苏苏州215123;2、苏州大学纺织与服装工程学院, 江苏苏州215021
收稿日期:2012-08-23
作者简介:孙飞翎(1988-),女,江苏常州人,在读研究生,主要从事纳米材料的制备及其在纺织品上的应用
通信作者:郑敏,E-mail:zhengmin@suda.edu.cn.
原载:印染助剂2013/8;20-22
【摘要】用轧烘焙法以及高温高压一浴法对涤纶织物进行纳米氧化钛后整理。采用扫描电镜观察织物的纤维表面,EDS进行元素分析。扫描电镜表明轧烘焙法得到的涤纶试样表面附着的氧化钛颗粒较少并且分布不均匀,有严重的团聚现象;而用高温高压一浴法得到的涤纶试样表面均匀地分布着较多的氧化钛颗粒;经过EDS元素分析也证实附着在纤维表面的材料为氧化钛。通过振荡法定量考察整理织物的抗菌性结果表明,轧烘焙法得到的试样没有抗菌性,高温高压一浴法得到的试样对金黄色葡萄球菌和大肠杆菌的抑菌率都在90%以上.对高温高压一浴法试样进行耐久性测试,经过10次、20次、50次水洗后,整理织物仍然具有较好的抗菌效果。
【关键词】纳米氧化钛;涤纶;抗菌
【中图分类号】TQ134.11 文献标识码:A 文章编号:1004-0439(2013)08-0020-03
随着社会的不断发展,传染病爆发频率明显增加.调查数据显示,每年死于细菌感染的有1 700万人,占全球死亡人数的1/3[1].纺织品面积大、易储存有机物,为细菌的生长提供了良好的环境,因此,纺织品可能会导致传染病的扩散。因此,抗菌已经被作为一项重要的纺织品后整理研究[2-3]。纳米氧化钛是一种催化活性高,氧化能力强的无机纳米材料[4],将纳米氧化钛整理到织物上,可赋予织物抗紫外线、抗菌等功能[5]。涤纶织物是目前使用最广泛的纺织材料之一,具有耐磨性好、保形性好、强度高等优点。若能将纳米氧化钛整理到涤纶织物上,可在很多领域开发出抗菌产品[6]。然而,相对于天然纤维,涤纶对纳米材料的亲和力弱,表面比较光滑,纳米材料很难整理到织物上,大多数情况下只能通过熔融纺丝赋予涤纶抗菌性,对纺丝技术及设备等要求较高。本文选择吸水性较好的改性涤纶为材料,用普通的轧烘焙法以及经过改进的高温高压一浴法对其进行后整理,比较了2种试验方法所得样品的各类性能。
1 试验
1.1 材料和仪器
材料:涤纶布;自制纳米氧化钛整理液(自制纳米氧化钛整理剂50 g/L,表面活性剂)。仪器:YXQ-LS-30SⅡ型立式压力蒸汽灭菌器(上海三申医疗器械有限公司),智能型试色机、焙烘机、轧车(厦门RAPID有限公
司),S-4700型冷电场扫描电镜(日本日立公司)。
1.2 整理工艺
轧烘焙法工艺:配制纳米整理液 超声分散20min→浸轧→烘干(100℃,5min)→焙烘(160℃,3 min)→水洗→烘干。
高温高压一浴法工艺:配制纳米整理液→超声分散20 min→将涤纶布置于纳米整理液中,于智能型试色机(涤纶高温高压染色机)内处理1 h(130℃)→烘干(100℃,5 min)→焙烘(160℃,3 min)→水洗→烘干。
1.3 测试
SEM:用扫描电镜对未处理和处理后的织物进行表征,对比处理前后纤维表面的纳米材料分布情况。
EDS:用能谱仪分别对未处理的样品以及2种工艺得到的样品进行元素分析,工作电压为150 kV。
抗菌性能:参照抗菌针织品纺织行业标准FZ/T73023-2006进行抗菌试验,测试方法选用振荡法,菌种为大肠杆菌和金黄色葡萄球菌.抑菌率计算公式如下:Y=(1-Wb/Wc)x100%.其中,Wb为标准空白试样振荡
接触18 h后烧瓶内的活菌浓度;Wc为抗菌织物试样或未抗菌织物试样振荡接触18 h后烧瓶内的活菌浓度。
耐洗性:按GB/T 8629-2001《纺织品试验用家庭洗涤和干燥程度》测试.用市售洗衣粉配制成洗涤液3 g/L,浴比1:30,常温下将织物放入洗衣机内洗10min,然后在清水中漂净作为一次洗涤。按此标准将整理织物分别水洗10次、20次、50次。
2 结果与讨论
2.1 SEM
从图1中可以看到,未处理的涤纶纤维表面光滑,只有少量的杂质存在.用轧烘焙法处理的涤纶纤维表面仅仅附着了少量的纳米材料,且分布不均匀,团聚现象比较严重,这是因为在轧烘焙工艺中添加的一些助剂使得纳米材料变得不稳定.而经过高温高压一浴法处理的涤纶纤维表面附着的纳米氧化钛较多,且分布均匀,说明在高温高压处理过程中纳米材料的颗粒团聚不严重.在高温高压一浴法试验过程中,由于没有使用过多的化学助剂,纳米氧化钛处理液在碱性条
件下能保持较好的稳定性,不易发生团聚.由于使用的纳米整理液为强碱性,纤维表面会产生一定的刻蚀,使纤维表面光滑度降低,从而增强对纳米材料的吸附性.与涤纶高温高压染色原理相似,在高温高压的条件下,纤维达到玻璃化温度以后,纤维大分子链段发生剧烈运动,聚合物分子间空隙增大,有利于纳米材料的附着.当试验结束后,温度降低,纤维分子链段运动停止,自由容积缩小,纳米材料便以氢键等作用力与纤维发生固着,并且具有一定的耐久性。
|
|
|
|
|
a-未处理; |
b-轧烘焙法整理; |
c-高温高压一浴法整理 |
|
图1 整理前后涤纶纤维的扫描电镜图 |
||
2.2 EDS
整理前后织物的EDS图见图2.
|
|
|
|
|
未整理 |
轧烘焙法整理 |
高温高压一浴法整理 |
|
图2 整理前后织物的EDS图 |
||

在4.510
keV处是钛元素的主峰.对比图2中3张图,可以发现.轧烘焙法工艺获得的织物能能谱图中钛元素主峰强度相对于未整理织物的基本没有变化,而高温高压一浴法获得的织物能谱中钛元素主峰的强度增强.离温高压一浴法得到的样品氧化钛含量比轧烘法得到的要高出许多。同时,能谱图中钛元素含量的明显增加,也可以证实,沉淀到纤维表面的颗粒为纳水TiO2。
2.3 抗菌性能
从图3、4中可以看出,用轧烘焙法得到的试佯菌落数仍然较多.只略少于标准白布,说明轧烘焙法得到的试样对金黄色葡萄球菌和大肠杆菌的抑菌效果较差。而通过高温高压一浴法得到的试佯菌落致明显少于标准白布,抑菌率都在90%以上,这说明整理织物对大肠杆菌和金黄色葡萄球菌都具有较好的抑制作用.并且由于金黄色葡萄球菌本身细胞壁较薄而更容易被杀死,对比图3c和图4c可以发现,金黄色葡萄球菌的菌落数更少,说明对金黄色葡萄球菌的抑制作用更好.
|
|
|
|
|
a-标准白布 |
b-轧烘焙法处理 |
c-高温高压一裕法处理 |
|
图3抗菌涤纶织物对金爵色葡萄球菌的抗菌效果 |
||
|
|
|
|
|
a-标准白布 |
b-轧烘焙法处理 |
c-高温高压一浴法处理 |
|
图4抗菌涤纶织物对大肠杆菌的抗菌效果 |
||
2.4 整理织物的耐洗性
从图5中可以看出,水洗10次、20次、50次后织物的纤维上仍然附着了纳米材料,但是水洗20次、50次后,纤维上纳米材料数量明显减少。
|
|
|
|
|
a-水洗lO次 |
b-水洗20次 |
c-水洗50次 |
|
图5东洗不同次数后涤纶纤维的扫描电镜图 |
||
从图6和图7中可以看出,水洗lO次后,整理织物对金黄色葡萄球菌和大肠杆菌的抑菌率都比较高,都在80%以上:经过20次水洗和50次水洗后.抑菌率都有所降低,基本在50%以上,说明整理后的抗菌涤纶效果显著,并且具有良好的耐洗性。
|
|
|
|
|
|
a-标准白布 |
b-水洗10次 |
c-水洗20次 |
d-水洗50次 |
|
图6水洗不同次数后织物对金黄色葡萄球菌的抑菌效果 |
|||
|
|
|
|
|
|
a-标准白布 |
b-水洗10次 |
c-水洗20状 |
d-水洗50次 |
|
图7水洗不同次数后织物对大肠杆菌的抑菌效果 |
|||
3 结论
通过轧烘焙法和高温高压一浴法对涤纶织物进行处理,将纳米氧化钛整理到织物上。结果表明,轧烘焙法得到的涤纶织物表面附着的纳米氧化钛含量少、分布不均匀;高温高压一浴法获得的涤纶织物表面附着的纳米氧化钛含量高、分布均匀、团聚少。抗菌性测试表明,轧烘焙法得到的织物抗菌性较差,高温高压一浴法得到的织物对大肠杆菌和金黄色葡萄球菌的抑菌率均在90%以上,且经过10、20、50次水洗后,抗菌性仍然较好。
参考文献:
[1]QIAN T,SU H,TAN
T The bacterial and mildew-Proof activity of a TiO2-chitosan
composite[J]Photochem.Photobiol A:Chem.2011,218:l30-136.
[2]黄晨,杨浦生,王红,等.棉织物的纳米TiO2,与SiO2抗紫外线整理[J]纺织学报,2096,27(8):12-15.
[3] MONTAZER M,SEIFOLLAHZADEH S
Enhanced seIf-cleaning,antibaeterial and UV protection properties of Ti02
treated textile through enzymatic pretreatment [J]Photochemistry and
Photobiology,20l1.87:877-883
[4]江海风,杨建忠,刘娜,纳米二氧化钛整理织物的自清洁和抗菌性能研究[J]纺织科技进展,2007(1):14-15.
[5]邓桦,邓宝祥,李秀明,等,棉织物纳米TiO2紫外线整理[J]纺织学报,2008,29(11):67-75
[6]邓桦,张纪梅.李秀明,等.纳米二氧化钛多功能织物整理剂的制 备与性能[J]纺织学报,2006.27(3):92-94